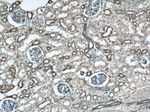
Annexin A11 Antibody in Immunohistochemistry (Paraffin) (IHC (P))

Search
Proteintech
Annexin A11 Polyclonal Antibody
{{$productOrderCtrl.translations['antibody.pdp.commerceCard.promotion.promotions']}}
{{$productOrderCtrl.translations['antibody.pdp.commerceCard.promotion.viewpromo']}}
{{$productOrderCtrl.translations['antibody.pdp.commerceCard.promotion.promocode']}}: {{promo.promoCode}} {{promo.promoTitle}} {{promo.promoDescription}}. {{$productOrderCtrl.translations['antibody.pdp.commerceCard.promotion.learnmore']}}
产品信息
10479-2-AP
种属反应
已发表种属
宿主/亚型
分类
类型
抗原
偶联物
形式
浓度
规格
纯化类型
保存液
内含物
保存条件
运输条件
产品详细信息
Immunogen sequence: MSYPGYPPP PGGYPPAAPG GGPWGGAAYP PPPSMPPIGL DNVATYAGQF NQDYLSGMAA NMSGTFGGAN MPNLYPGAPG AGYPPVPPGG FGQPPSAQQP VPPYGMYPPP GGNPPSRMPS YPPYPGAPVP GQPMPPPGQQ PPGAYPGQPP VTYPGQPPVP LPGQQQPVPS YPGYPGSGTV T (1-180 aa encoded by BC007564)
靶标信息
This gene encodes a member of the annexin family, a group of calcium-dependent phospholipid-binding proteins. Annexins have unique N-terminal domains and conserved C-terminal domains, which contain the calcium-dependent phospholipid-binding sites. The encoded protein is a 56-kD antigen recognized by sera from patients with various autoimmune diseases. Transcript variants encoding the same isoform have been identified.
仅用于科研。不用于诊断过程。未经明确授权不得转售。
生物信息学
蛋白别名: 56 kDa autoantigen; Annexin A11; Annexin A11 (Annexin XI) (Calcyclin-associated annexin 50) (CAP-50); Annexin XI; Annexin-11; ANXA11; autoantigen; Calcyclin-associated annexin 50; CAP-50; epididymis secretory sperm binding protein; OTTHUMP00000019957; OTTHUMP00000019958; RP11-369J21; unnamed protein product
基因别名: A830099O17Rik; ALS23; ANX11; ANXA11; CAP-50; CAP50; IBMWMA
UniProt ID: (Human) P50995, (Mouse) P97384
Entrez Gene ID: (Human) 311, (Rat) 290527, (Mouse) 11744